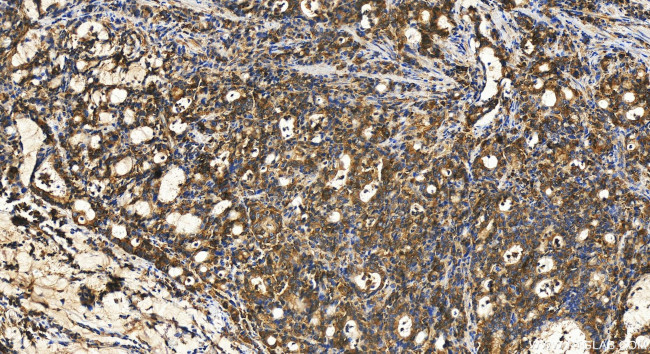
YARS Antibody in Immunohistochemistry (Paraffin) (IHC (P))

Search
Proteintech
YARS Polyclonal Antibody
{{$productOrderCtrl.translations['antibody.pdp.commerceCard.promotion.promotions']}}
{{$productOrderCtrl.translations['antibody.pdp.commerceCard.promotion.viewpromo']}}
{{$productOrderCtrl.translations['antibody.pdp.commerceCard.promotion.promocode']}}: {{promo.promoCode}} {{promo.promoTitle}} {{promo.promoDescription}}. {{$productOrderCtrl.translations['antibody.pdp.commerceCard.promotion.learnmore']}}
产品信息
31228-1-AP
种属反应
宿主/亚型
分类
类型
抗原
偶联物
形式
浓度
规格
纯化类型
保存液
内含物
保存条件
运输条件
产品详细信息
Immunogen sequence: RTVVSGLVQF VPKEELQDRL VVVLCNLKPQ KMRGVESQGM LLCASIEGIN RQVEPLDPPA GSAPGEHVFV KGYEKGQPDE ELKPKKKVFE KLQADFKISE ECIAQWKQTN FMTKLGSISC KSLKGGNIS
靶标信息
Aminoacyl-tRNA synthetases catalyze the aminoacylation of tRNA by their cognate amino acid. Because of their central role in linking amino acids with nucleotide triplets contained in tRNAs, aminoacyl-tRNA synthetases are thought to be among the first proteins that appeared in evolution. Tyrosyl-tRNA synthetase belongs to the class I tRNA synthetase family. Cytokine activities have also been observed for the human tyrosyl-tRNA synthetase, after it is split into two parts, an N-terminal fragment that harbors the catalytic site and a C-terminal fragment found only in the mammalian enzyme. The N-terminal fragment is an interleukin-8-like cytokine, whereas the released C-terminal fragment is an EMAP II-like cytokine.
仅用于科研。不用于诊断过程。未经明确授权不得转售。
篇参考文献 (0)
生物信息学
蛋白别名: tyrosine tRNA ligase 1, cytoplasmic; Tyrosine--tRNA ligase, cytoplasmic; tyrosyl trna synthetase; tyrosyl--tRNA ligase; Tyrosyl-tRNA synthetase; tyrosyl-tRNA synthetase, cytoplasmic; TyrRS; unnamed protein product
基因别名: CMTDIC; IMNEPD2; TYRRS; YARS; YARS1; YRS; YTS
UniProt ID: (Human) P54577
Entrez Gene ID: (Human) 8565